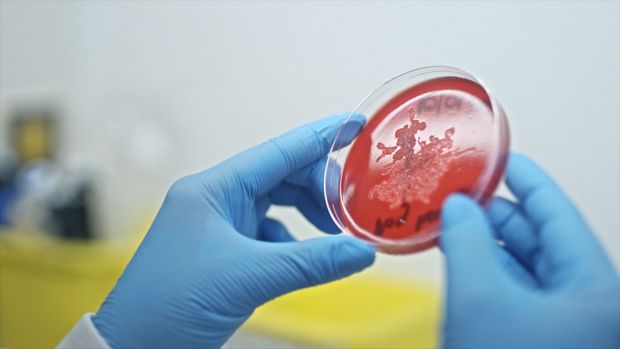

쿠키 설정
다이슨 웹 사이트는 쿠키를 사용하며, 당사의 사이트를 계속 방문함으로써 귀하의 장치에 쿠키가 저장될 수 있음을 허용합니다.
저희가 사용하는 쿠키의 자세한 내용 및 삭제나 차단에 관해서는 쿠키 취급 방침을 참고해 주시기 바랍니다.


코로나19 팬데믹 이후, 복슬복슬한 털을 가진 귀여운 반려동물을 가족으로 맞이하게 된 가정이 급격히 늘어났습니다. 반려동물은 우리에게 행복과 즐거움을 주기도 하지만, 동시에 집 안으로 작은 불청객을 데려오기도 합니다. 반려동물의 비듬이라고 불리는 피부 각질은 육안으로 확인하기 어렵지만, 실내 공기 오염의 원천이 될 수 있습니다. 다이슨의 미생물학팀은 첨단 연구 시설에서 반려동물의 털과 비듬, 그리고 알레르기 유발 물질이 어떻게 우리와 우리의 주변 환경에 영향을 미치는지 매우 오랜 시간동안 연구해 왔습니다. 미생물학팀은 더 건강한 가정 환경을 조성하기 위한 기술 개발에 필요한 연구를 진행하고 있습니다. 그럼, 미생물학 팀이 발견한 사실을 소개합니다.
한 연구에 따르면, 전 세계 인구의 57%가 반려동물을 기르고 있으며,1 이 수는 계속 증가하고 있습니다 한국의 경우 반려 동물을 키우는 반려가구는 604만 가구로 한국 전체 가구의 29.7%를 차지하고, 한국인 4명 중 1명 이상이 반려동물과 살아가고 있습니다.2 이 중 반려동물로 인한 알레르기를 겪고 있는 사람들도 꽤나 많을텐데요, 반려동물과 시간을 보내고 가려움증이 생긴 사람들의 대부분은 이 가려움증의 원인이 반려동물의 털이라고 오해하곤 합니다. 그러나 사실 가려움증의 진짜 원인은 반려동물의 털에 있는 단백질과 침, 소변 또는 대변에서 나오는 알레르기 유발 물질입니다.
반려동물이 혼자 그루밍을 할 때, 반려동물의 침에서 알레르기 반응을 유발하는 미세한 단백질 입자들이 묻어나와 털과 피부에 축적될 수 있습니다. 3 반려동물의 피부 세포는 일정 주기로 건조해지고 피부에서 탈락하여 비듬이 되는데요, 그 과정에서 털과 피부 여기저기로 옮겨집니다. 반려동물의 비듬은 그 미세한 크기 때문에 특히 문제가 될 수 있습니다. 미세한 크기의 비듬과 함께 알레르기를 유발하는 단백질이 공기 중에 떠다니며 집안에 퍼지게 되고, 물체 표면에 쌓일 수도 있기 때문입니다.4

하이포알러제닉(저알레르기) 반려동물이라고 불리는 반려동물의 인기가 높아지고 있지만, 사실상 반려동물 알레르기가 있는 사람들에게 알레르기를 유발하지 않는 고양이나 강아지는 없습니다. 털이 훨씬 덜 빠지는 품종들이 있지만, 털이 없는 동물조차도 공기 중에 비듬과 알레르기 유발 물질을 퍼뜨릴 수 있습니다.5
다이슨의 미생물학자, 모니카 스투첸(Monika Stuczen)은 반려동물의 행동을 더 잘 이해하기 위해 반려동물의 털을 연구하는 과학자입니다.
“대부분의 반려동물 비듬은 육안으로 확인하기 어렵습니다. 그리고 비듬은 독특한 공기역학적 특성을 가지고 있습니다. 가볍고 미세한 크기로 인해 공기 중에 떠다니거나 집안 구석구석에 쌓일 수 있습니다. 몇 시간 동안 공기 중에 떠 있을 수 있고, 심지어 호흡을 통해 흡입될 수도 있습니다. 삐죽삐죽한 모양을 가졌기 때문에 가구와 침구, 패브릭 및 집 안팎으로 운반되는 물품에 쉽게 달라붙을 수도 있습니다. 살짝 건드리기만 해도 공기 중으로 전파될 수 있으며, 오랜 시간 공기 중에 머물기도 합니다. 게다가 비듬은 집먼지진드기의 먹이로, 집먼지진드기들이 증식하며 공기 중에 떠다닐 수 있는 알레르기 유발 물질을 더 많이 만들어 내어 알레르기 환자들에게 더 심각한 문제를 야기할 수 있습니다”
다이슨 엔지니어들은 미생물학 연구소를 통해 반려동물이 집먼지에 미치는 영향에 대해 더 잘 이해할 수 있게 되었습니다. 이를 통해 다이슨의 제품으로 먼지와 반려동물의 비듬을 효과적으로 청소하고, 집 안에 더 깨끗해진 공기를 배출하기 위한 기술을 개발할 수 있었습니다.
연구의 일환으로, 다이슨의 미생물학자들은 첨단 주사전자현미경(SEM, Scanning Electron Microscope)으로 포착한 동물의 털 이미지를 모아 라이브러리를 만들었습니다. 이 데이터베이스에는 고양이와 강아지뿐만 아니라 알파카, 당나귀, 말, 토끼와 같은 다양한 동물들의 털 이미지가 저장되어 있습니다.
연구팀은 데이터베이스를 통해 동물의 종과 품종에 따른 털의 크기, 질감과 구조는 물론, 가정에 퍼질 수 있는 보이지 않는 알레르기 유발 물질과 박테리아에 대해 깊이 이해할 수 있었습니다.

래브라도 리트리버: 가시가 있는 비늘무늬, 고양이 털과 유사함

보스턴 테리어: 사람의 모발과 비슷한 비늘무늬

고양이 털(앞)과 비교한 사람의 모발(뒤)의 SEM 이미지
사진과 같이, 고양이의 털은 사람의 모발보다 평균 33% 더 가는 두께를 가지고 있습니다.

말 털의 샘플에서도 미세한 파편들을 무수하게 많이 확인할 수 있습니다. 이 파편들은 알레르기를 유발하는 단백질일 수 있습니다.

고양이 털과 비듬
고양이 털에 알레르기 유발 물질이 있을 확률이 개의 털보다 약 두 배 가량 많습니다. 일반적으로 고양이가 개보다 깨끗하다는 인식이 있지만, 고양이들은 훨씬 더 규칙적으로 털 손질을 하기 때문에 털에 더 많은 비듬이 붙어 있게 됩니다.
다이슨의 미생물학자들은 반려동물의 털 주변에 서식하는 박테리아 군체의 성장을 관찰하기 위해 세균배양에 사용하는 한천평판(Agar plate)을 사용하기도 했습니다. 빠르게 성장하는 세균일수록 알레르기를 유발하는 단백질일 가능성이 높습니다.
다이슨 엔지니어들은 이번 연구를 통해 가정 내 먼지의 구성 요소에는 육안으로 확인이 가능한 반려동물의 털과, 육안으로는 확인이 어려운 비듬이 있다는 것을 더 잘 이해할 수 있었습니다. 이러한 연구 결과는 다이슨의 최신 청소기 기술과 툴에 적용되어 실제 소비자들이 가정에서 겪는 문제를 해결하도록 설계되었습니다.
다이슨의 최신 엉킴 방지 모터바™ 클리너 헤드에는 정교한 각도로 설계된 브러쉬가 내장되어 있어 브러쉬바에서 자동으로 엉킨 반려동물의 털과 머리카락을 풀어줍니다.7 폴리카보네이트로 만들어진 이 엉킴 방지 브러쉬와 나선형의 나일론 브러쉬, 정전기를 방지하는 카본 파이버 필라멘트 및 다이슨 무선 청소기의 강력한 흡입력8이 반려동물의 털과 머리카락 엉킴을 풀어주고, 큰 입자부터 미세한 크기의 먼지까지 구석구석 청소합니다.
다이슨 무선 청소기와 호환이 가능한9 다이슨 펫 그루밍 툴은 35° 각도로 설계된 364개의 브러쉬가 장착되어 있어, 반려동물을 빗질하면서 빠진 털과 비듬을 바로 잡아내기 때문에 집안 곳곳에 털과 비듬이 퍼지는 것을 방지하도록 도와줍니다.10
다이슨의 최신 무선 청소기 제품은 강력한 흡입력으로 먼지와 이물질, 그리고 반려동물의 털을 먼지통으로 흡입하는 동시에 제품 전체에 적용된 고성능 필터레이션11으로 집안에 더 깨끗해진 공기를 배출합니다. 다이슨의 고성능 필터레이션 기술은 0.3 마이크론만큼 작은 미세한 크기의 먼지 입자의 99.99%를 제거한 후 가둬 둡니다.11 참고로, 꽃가루 입자의 크기는 약 10마이크론이며, 0.3마이크론은 반려동물의 비듬보다 16배 작은 크기입니다.